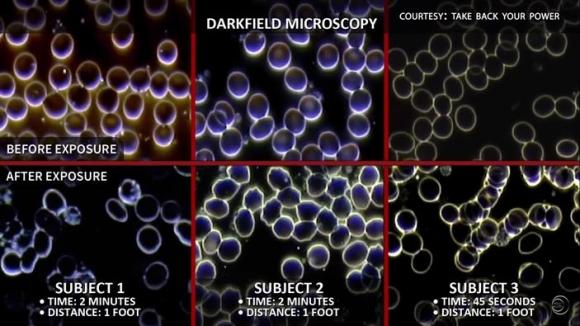
42 5 Chung Ta Chua Co Ly Do De Tin Rang Cong Nghe 5g An Toan Doi Voi Suc Khoe

Một bài bình luận có tựa đề “Chúng ta chưa có lý do để tin rằng mạng 5G là an toàn (đối với sức khỏe)” trên tạp chí Scientific American ngày 17/10/2019 của TS Joel M. Moskowitz – giám đốc Trung tâm Sức khỏe Gia đình và Cộng đồng tại Trường Y tế Công cộng tại Đại học California, Berkeley (Mỹ) – đã đưa ra một cái nhìn khái quát về vấn đề này.
Dưới đây là nội dung bài bình luận:
Chúng ta chưa có lý do để tin rằng công nghệ 5G an toàn đối với sức khỏe
Ngành công nghiệp viễn thông và các chuyên gia trong ngành đã cáo buộc nhiều nhà khoa học tiến hành nghiên cứu tác động của bức xạ điện thoại di động là đang tỏ ra “sợ hãi quá trớn” trước sự ra đời của mạng công nghệ không dây 5G.
Bởi phần lớn nghiên cứu của chúng tôi được tài trợ công khai, chúng tôi tin rằng trách nhiệm đạo đức của mình là thông báo cho công chúng về những rủi ro sức khỏe của bức xạ không dây từ kết luận của các tài liệu khoa học bình duyệt.

Sự phát triển của công nghệ (Ảnh chụp màn hình Youtube/phim 5G APOCALYPSE – THE EXTINCTION EVENT/New Earth Project).
Chủ tịch Ủy ban Truyền thông Liên bang (FCC) – một cơ quan độc lập trong Chính phủ Hoa Kỳ chuyên môn về những vấn đề truyền thông – mới đây đã thông báo trong một thông cáo báo chí rằng ủy ban này sẽ sớm tái ban hành lại (giữ nguyên) các mức giới hạn phơi nhiễm bức xạ tần số vô tuyến (radio frequency radiation – RFR) mà FCC đã thông qua vào cuối thập niên 90 của thế kỷ trước. Những mức giới hạn này được dựa trên sự thay đổi hành vi ở chuột tiếp xúc với bức xạ vi sóng và được thiết kế để bảo vệ chúng ta khỏi những rủi ro nhiệt lượng ngắn hạn từ loại bức xạ này do phơi nhiễm RFR.
Tuy nhiên, kể từ khi FCC áp dụng các mức giới hạn này chủ yếu dựa trên nghiên cứu từ những năm 1980, một số lượng đáng kể các nghiên cứu bình duyệt, khoảng hơn 500 nghiên cứu bình duyệt đã tìm thấy các tác động sinh học hoặc sức khỏe có hại khi phơi nhiễm với RFR ở cường độ thấp hơn rất nhiều so với cường độ sinh nhiệt (cường độ làm nóng) thông thường.
Viện dẫn khối lượng nghiên cứu lớn này, hơn 240 nhà khoa học từng đăng tải nghiên cứu bình duyệt về tác dụng sinh học và sức khỏe của trường điện từ không kích thích (EMF) đã ký tên vào Bản đề xuất của các nhà khoa học quốc tế về EMF ( International EMF Scientist Appeal ), kêu gọi thiết lập các mức giới hạn phơi nhiễm chặt chẽ hơn. Bản đề xuất đưa ra những nhận định sau:
“Rất nhiều ấn phẩm khoa học gần đây đã chỉ ra rằng EMF ảnh hưởng đến các sinh vật sống ở mức độ thấp hơn hầu hết các chỉ dẫn ở tầm quốc gia và quốc tế. Các tác động bao gồm sự gia tăng nguy cơ ung thư, căng thẳng tế bào, gia tăng các gốc tự do có hại, tổn thương di truyền, thay đổi cấu trúc và chức năng hệ sinh sản, khả năng học tập và ghi nhớ sa sút, rối loạn thần kinh và tác động tiêu cực đến sức khỏe nói chung ở người. Các tổn hại không chỉ ghi nhận ở người, khi ngày càng có nhiều bằng chứng về tác hại đối với cả thực vật và động vật”.
Phần lớn các chuyên gia về ảnh hưởng của bức xạ không kích thích đối với sức khỏe con người đều có tên trong bản đề xuất này. Những chuyên gia này đã xuất bản hơn 2.000 bài viết về EMF trên các tạp chí chuyên ngành.
Giới hạn phơi nhiễm RFR của FCC được điều chỉnh dựa trên cường độ phơi nhiễm, có tính đến tần số của mức sóng nhà mạng, nhưng lại không tính đến các đặc tính tín hiệu của RFR. Bên cạnh khuôn mẫu và thời gian phơi sáng, một số đặc điểm nhất định của tín hiệu (ví dụ: xung, phân cực) sẽ làm gia tăng các tác động sinh học và sức khỏe của tình trạng phơi nhiễm. Do đó cần thiết lập các mức giới hạn phơi nhiễm mới để bao hàm các hiệu ứng khác biệt này. Hơn nữa, những giới hạn này phải được dựa trên các tác động sinh học, chứ không phải đơn thuần dựa trên sự thay đổi hành vi của chuột trong phòng thí nghiệm.
Cơ quan Nghiên cứu Ung thư Quốc tế của Tổ chức Y tế Thế giới (IARC) đã liệt bức xạ RFR vào loại “tiềm ẩn nguy cơ gây ung thư ở người” vào năm 2011. Năm ngoái, một nghiên cứu trị giá 30 triệu USD, kéo dài 10 năm được tiến hành bởi Chương trình Chất độc Quốc gia Hoa Kỳ (NTP) đã tìm thấy “bằng chứng rõ ràng” rằng chỉ cần hai năm phơi nhiễm với bức xạ RFR của điện thoại di động là có thể làm gia tăng nguy cơ ung thư ở chuột đực và làm tổn hại DNA ở loài chuột cả hai giới. Viện Ramazzini ở Ý đã tiến hành thí nghiệm độc lập và đi đến cùng một kết luận căn bản tương đương của NTP bằng cách sử dụng một tần số sóng mạng khác và mức độ phơi nhiễm với bức xạ điện thoại di động yếu hơn khá nhiều.
Dựa trên nghiên cứu công bố năm 2011, bao gồm các nghiên cứu về người và động vật và dữ liệu cơ học, IARC gần đây đã ưu tiên việc xét duyệt lại RFR trong 5 năm tới. Vì nhiều nhà khoa học EMF tin rằng chúng ta hiện có đủ bằng chứng để coi RFR là chất gây ung thư tiềm năng hoặc đã biết ở người, IARC có thể sẽ gia tăng mức độ gây ung thư tiềm ẩn của RFR trong tương lai gần.
Xem biểu đồ tế bào máu của người trước và sau khi tiếp xúc với các đồng hồ đo thông minh (smart meter), trong 1 thí nghiệm gồm 30 người của bác sĩ Frank Springob.
 Biểu đồ trước khi phơi nhiễm của các tế bào máu của 3 đối tượng (ảnh chụp màn hình Youtube/phim 5G APOCALYPSE – THE EXTINCTION EVENT/New Earth Project).
Biểu đồ trước khi phơi nhiễm của các tế bào máu của 3 đối tượng (ảnh chụp màn hình Youtube/phim 5G APOCALYPSE – THE EXTINCTION EVENT/New Earth Project). Biểu đồ sau khi phơi nhiễm của các tế bào máu của 3 đối tượng. Trong cả 3 trường hợp, đều ghi nhận sự thoái hóa (thương tích) của các tế bào máu (ảnh chụp màn hình Youtube/phim 5G APOCALYPSE – THE EXTINCTION EVENT/New Earth Project).
Biểu đồ sau khi phơi nhiễm của các tế bào máu của 3 đối tượng. Trong cả 3 trường hợp, đều ghi nhận sự thoái hóa (thương tích) của các tế bào máu (ảnh chụp màn hình Youtube/phim 5G APOCALYPSE – THE EXTINCTION EVENT/New Earth Project). Biểu đồ kết hợp. Nửa trên: Trước phơi nhiễm. Nửa dưới: Sau phơi nhiễm (ảnh chụp màn hình Youtube/phim 5G APOCALYPSE – THE EXTINCTION EVENT/New Earth Project).
Biểu đồ kết hợp. Nửa trên: Trước phơi nhiễm. Nửa dưới: Sau phơi nhiễm (ảnh chụp màn hình Youtube/phim 5G APOCALYPSE – THE EXTINCTION EVENT/New Earth Project).
Tuy vậy, dù không thực hiện đánh giá rủi ro chính thức hoặc đánh giá có hệ thống về các nghiên cứu về ảnh hưởng đến sức khỏe của RFR, FDA gần đây đã tái khẳng định quyết định muốn giữ nguyên mức giới hạn phơi nhiễm năm 1996 của FCC trong một lá thư gửi cho FCC, khi cho biết cơ quan này “đã kết luận rằng không có sự thay đổi nào đối với các tiêu chuẩn hiện hành là hợp lý tại thời điểm hiện nay”, và rằng “những kết quả thử nghiệm của NTP không nên được áp dụng cho việc sử dụng điện thoại di động trên người”. Bức thư nói rằng, “cho đến nay các bằng chứng khoa học hiện tại không cho thấy các tác động sức khỏe bất lợi đối với người do phơi nhiễm tại hay ở dưới các mức giới hạn phơi nhiễm hiện tại”.
Công nghệ di động mới nhất hiện nay, 5G, sẽ lần đầu tiên sử dụng sóng milimet, song hành với vi sóng vốn được sử dụng cho các công nghệ di động cũ hơn, từ thế hệ 2G đến 4G. Với phạm vi tiếp cận hạn chế, việc hiện thực hóa 5G sẽ yêu cầu thiết lập ăng-ten di động cứ sau 100 đến 200 mét, khiến nhiều người bị phơi nhiễm trước bức xạ sóng milimet. 5G cũng sử dụng các công nghệ mới (ví như ăng ten có khả năng hình thành chùm tia, mảng pha, nhiều đầu vào và đầu ra lớn, được gọi là các MIMO lớn) đặt ra những thách thức đặc thù trong trong việc đo lường mức độ phơi nhiễm.
Sóng milimet chủ yếu được hấp thụ trong vòng một vài milimet cách da người và trong các lớp bề mặt của giác mạc. Việc tiếp xúc ngắn hạn có thể mang đến tác dụng sinh lý bất lợi đối với hệ thần kinh ngoại biên, hệ miễn dịch và hệ tim mạch. Nghiên cứu cho thấy việc tiếp xúc lâu dài có thể gây ra các rủi ro cho sức khỏe của da (ví dụ, khối u ác tính), mắt (ví dụ, khối u ác tính ở mắt) và tinh hoàn (ví dụ, sự vô sinh).
Bởi 5G là một loại công nghệ mới, do đó chưa có nghiên cứu về ảnh hưởng đối với sức khỏe của nó. Tuy nhiên, chúng ta đã có nhiều bằng chứng về tác hại của sóng 2G và 3G. Người ta biết rất ít về những ảnh hưởng của việc phơi nhiễm với sóng 4G, một công nghệ đã có 10 năm tuổi, bởi các chính phủ khá chểnh mảng trong việc tài trợ cho nghiên cứu này.
Cùng lúc, chúng ta đang chứng kiến sự gia tăng một số loại khối u ở đầu và cổ trong hệ thống dữ liệu về ung thư, có thể ít nhất một phần là do sự gia tăng của bức xạ điện thoại di động. Những sự gia tăng này tương thích với kết quả từ các nghiên cứu kiểm soát về nguy cơ ung thư ở người dùng điện thoại di động nặng.
5G sẽ không thay thế 4G; nó sẽ đồng hành cùng 4G trong tương lai gần và có thể trong thời gian dài. Nếu có tác động hiệp đồng từ tình trạng phơi nhiễm bức xạ đồng thời đến từ nhiều loại RFR, thì nguy cơ gây hại chung từ RFR có thể gia tăng đáng kể. Ung thư không phải là nguy cơ duy nhất vì có bằng chứng đáng kể cho thấy RFR gây ra tình trạng rối loạn thần kinh và tổn hại sinh sản, có khả năng là do stress oxy hóa.
Là một xã hội, chúng ta có nên đầu tư hàng trăm tỷ đô la để triển khai mạng 5G, một công nghệ di động đòi hỏi phải lắp đặt 800.000 ăng ten di động mới ở Mỹ, ngay cạnh những nơi chúng ta sinh sống, làm việc và vui chơi hay không?
Thay vào đó, chúng ta nên ủng hộ khuyến nghị của 250 nhà khoa học và bác sĩ y khoa đã ký bản đề xuất 5G kêu gọi một lệnh trì hoãn tức thì đối với việc triển khai 5G và yêu cầu chính phủ tài trợ cho nghiên cứu cần thiết để thiết lập các giới hạn phơi nhiễm sinh học nhằm bảo vệ sức khỏe và sự an toàn của chúng ta.
Theo Scientific American
Quý Khải biên dịch




















Ý kiến bạn đọc